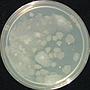
Nature's Ocean Nutri Sea Live Water Acqua Marina pronta all'uso 16.67 Lt

Nature's Ocean Nutri Sea Live Water Acqua Marina pronta all'uso 16.67 Lt
Vantaggi dell'acqua Nutri Sea Water :
• Nessuna attesa ... si possono inserire da subito i pesci!
• Nutri Sea Water viene filtrata naturalmente per non rimuovere o modificare quello che è presente in natura.
• 100% naturale in direttamente da Oceani Tropicali
• Contiene i naturali Batteri marini Eterotrofi, autotrofi ed chemiotrofici, per fornire un adeguato equilibrio inorganico.
• Arricchito con QX-23 Enrinched in soluzione
• Riduce la necessità di ulteriori prodotti per il trattamento di acqua salata.
• Nessuna miscelazione richiesta
• Mantiene il corretto pH, fornendo una migliore capacità tampone.
Uso consigliato per la Nutri Sea Water:
Nutri Sea Water può essere anche aggiunta ad acque sintetiche classiche per fornire batteri VIVI eterotrofi marini naturali, oligoelementi naturali e nutrienti essenziali naturali necessarii "per un acquario sano".
Per risultati ottimali utilizzare il 100% Nutri Sea Water.
Informazioni:
È molto importante nella manutenzione di un acquario marino che l'ambiente venga rifornito regolarmente. Il modo migliore per raggiungere questo obiettivo è cambiare il 15-20 percento dell'acqua una volta al mese. L'acqua sostitutiva ideale è l'acqua salata oceanica naturale al 100%. L'acqua salata naturale dell'oceano contiene tutti gli elementi essenziali e i micronutrienti richiesti da pesci, coralli e invertebrati che popolano il tuo acquario. Inoltre, l'acqua naturale dell'oceano contiene i batteri LIVE® necessari per la rapida rimozione dei rifiuti biologici. Un processo critico nella creazione di un nuovo sistema di acquari marini è la coltura di batteri sufficienti per abbattere adeguatamente i prodotti di scarto. La nitrificazione è il primo passo in questo importantissimo processo. La nitrificazione viene effettuata da gruppi non correlati di batteri eterotrofi e chemolitotrofi. Il primo gruppo converte l'ammoniaca in nitrito, che viene poi convertito in nitrato dal secondo gruppo. I catalizzatori più noti di queste reazioni sono rispettivamente Nitrosomonas e Nitrobacter, sebbene siano stati identificati anche altri gruppi (Belser 1979, Bergeys 1989). Presi insieme, questi batteri possono essere utilizzati per migliorare i danni all'ambiente dell'acquario riducendo il contenuto di ammoniaca, che viene generato come rifiuto biologico. Un'efficace rimozione dell'ammoniaca è estremamente importante poiché l'ammoniaca è tossica per la vita acquatica e crea una grande richiesta di ossigeno (USEPA 1993).
Nature's Ocean® Live ® Nutri-Seawater® contiene batteri planctonici® vivi e naturali, che lo rendono il miglior prodotto per i cambi mensili dell'acqua. Nutri-Seawater® può rimuovere immediatamente i prodotti di scarto biologici che si sono accumulati nell'ambiente dell'acquario e, poiché contiene batteri vivi, può ridurre rapidamente la generazione di nuovi prodotti di scarto.
Per le nuove configurazioni dell'acquario: per ottenere Instant Cycling® utilizzare Nature's Ocean® Bio-Activ Live® Aragonite Reef Sand o Substrato.